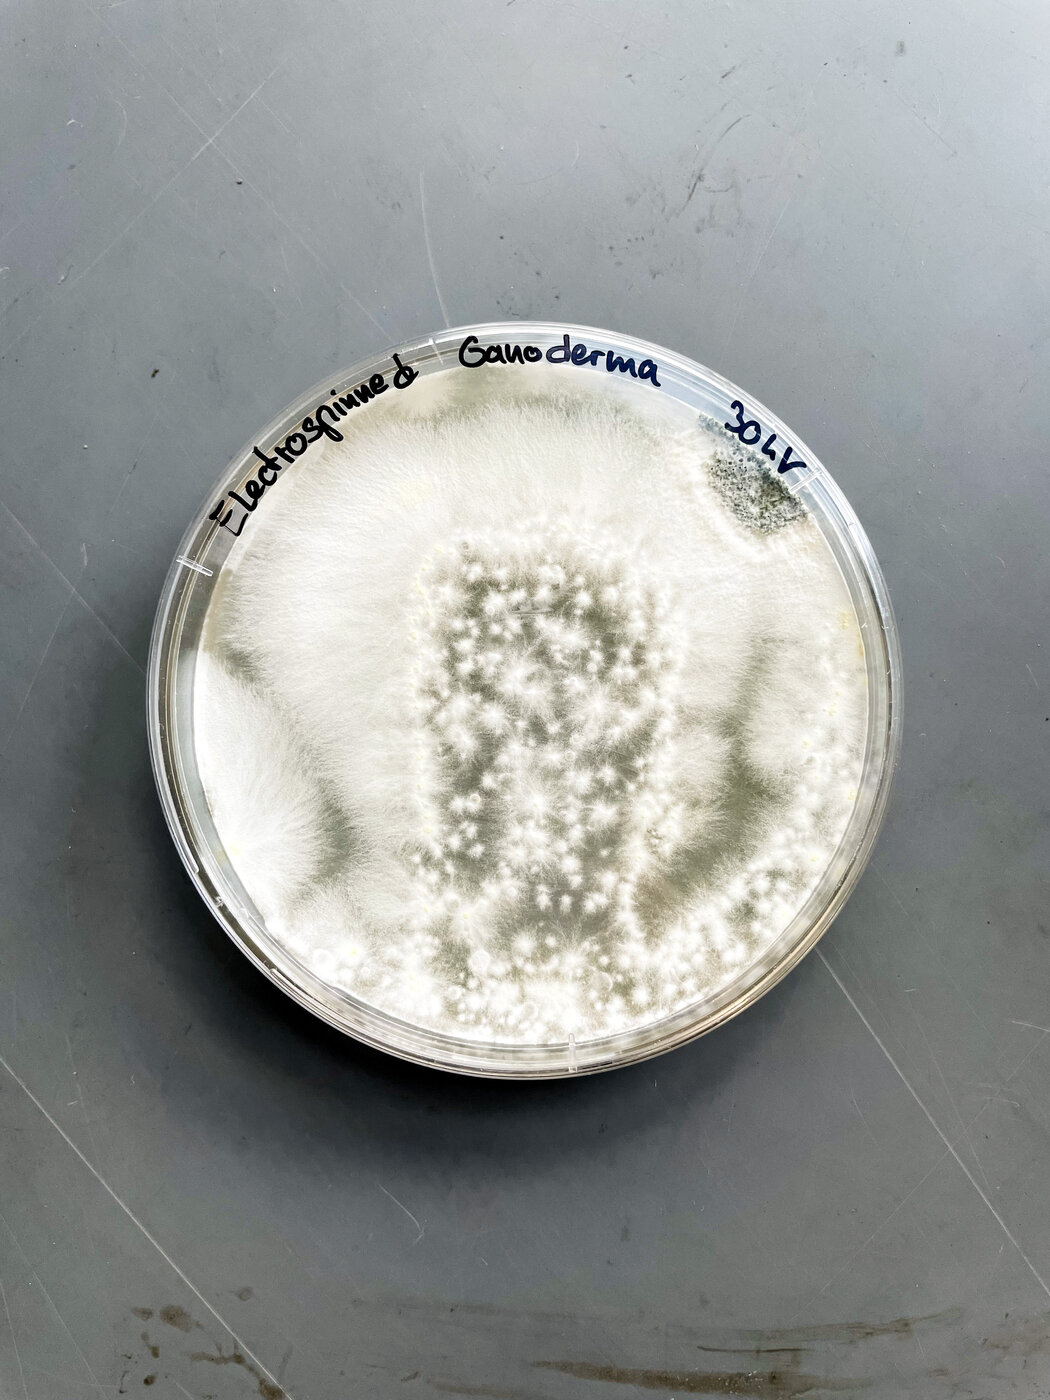
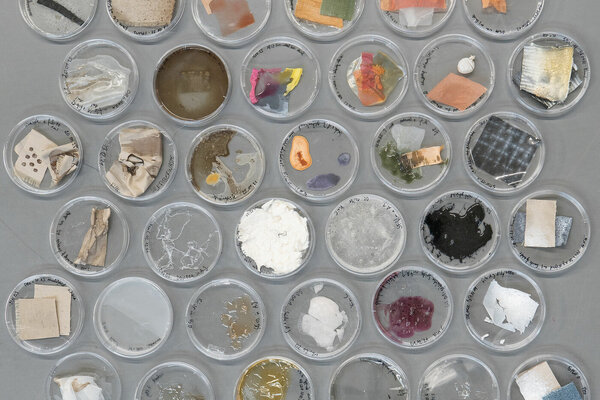

Wie sieht ein lebendes Material aus? Wie lassen sich seine Mikrohabitate gestalten? Welchen Spielraum geben wir dem lebenden Material? Formt es sich selbst? Was würde passieren, wenn Materialien zu symbiotischen Partnern würden? Was bedeutet ihre Vergänglichkeit für Materialkreisläufe?
In dem Projekt werden lebende Mikroorganismen in Materialien, Membranen und textile Oberflächen eingebettet. Durch die experimentelle Verknüpfung von Textiltechnologien – konventioneller Siebdruck, Beschichtungen oder Färben und spezielle Elektrospinnverfahren zur Herstellung von Nanofasern – mit biotechnologischen Verfahren untersucht das Projekt «Living Layers» die Potenziale, die sich aus symbiotischen (Schicht-)Systemen ergeben – und auch die Konflikte, die mit mikrobiell aktiven Oberflächen und Schichten einhergehen. Welche Rolle können eingebettete Mikroorganismen spielen? Ermöglichen sie überhaupt erst die Materialbildung und wachsen sie nach Bedarf weiter? Verändern sie Struktur, Festigkeit, Form, Aussehen, Farbe? Interagieren sie mit der Umgebung?
Die Aufgabe bestand darin,
1. lebende Mikroorganismen durch den explorativen Einsatz textiler Technologien in Textilgewebe zu integrieren und so lebende Materialien, Oberflächen und Strukturen mit völlig neuen Eigenschaften zu entwerfen. Grundlage sind die bereits gewonnenen Erkenntnisse aus den letzten Residencies und der BioLab-Forschung.
2. daraus resultierende Fragen und Ideen im Umgang mit dem Lebendigen in Experimenten, möglichen Anwendungen und Szenarien zu präsentieren.
3. das Projekt und die Experimente im BioLab kontinuierlich dokumentieren und sie anderen Studierenden als Workshop und/oder Dokumentation zur Verfügung stellen.
Das Projekt ist Teil des Forschungskomplexes complex "Symbiotic Subjects – Beneficiary Relations and Interactions", der sich mit der Erforschung und Gestaltung symbiotischer Systeme und der damit verbundenen Mensch-Natur-Beziehung befasst.